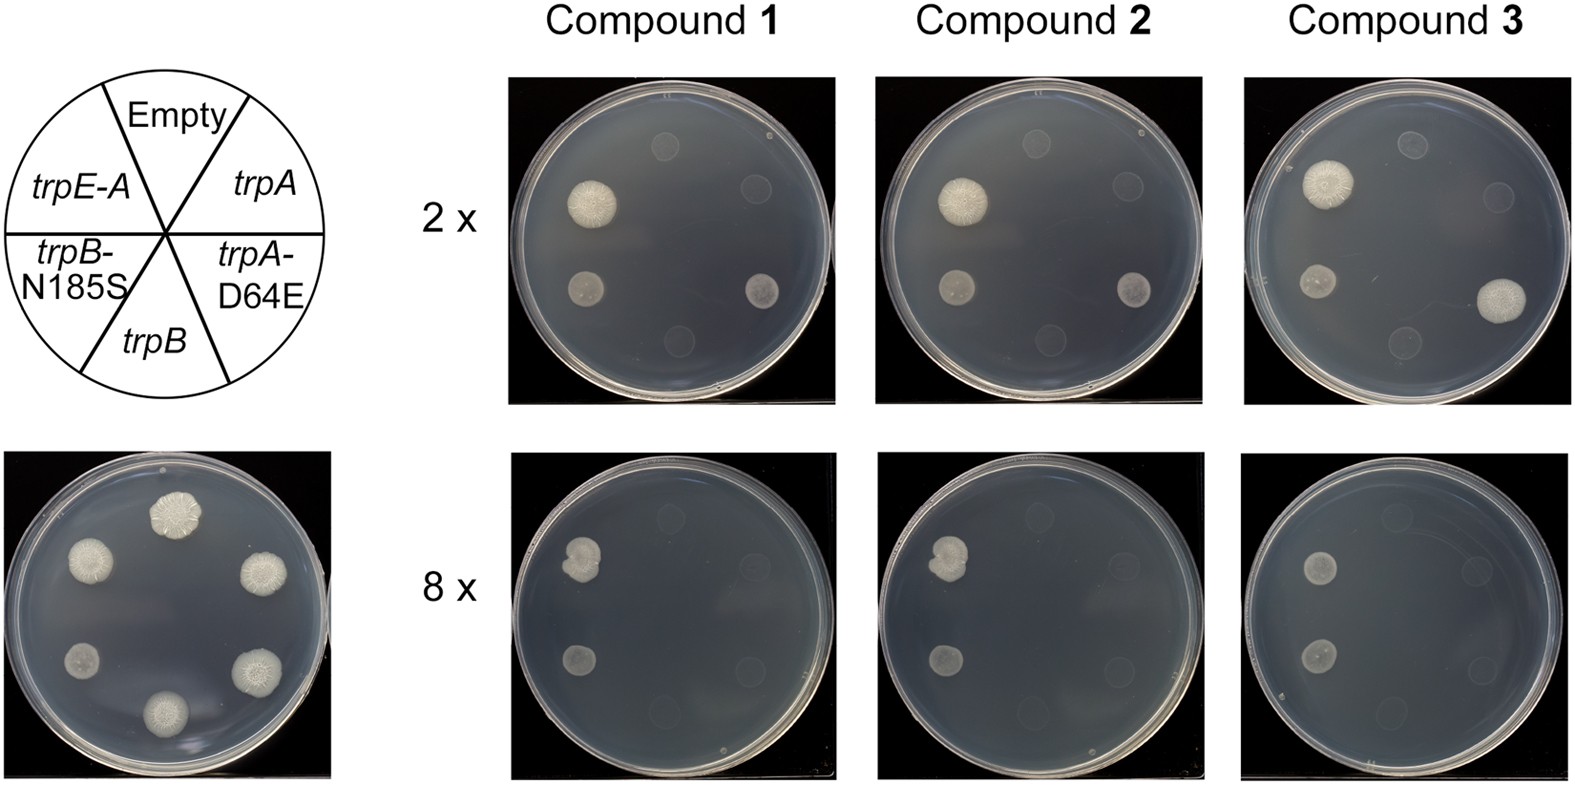
Figure 4

Figure 4
From: Inhibiting mycobacterial tryptophan synthase by targeting the inter-subunit interface
Impact on inhibitor MIC upon over-expression of tryptophan synthase subunits. The MICs of compounds 1, 2 and 3 were analyzed with M. bovis BCG over-expressing the following pVV16 constructs: empty, trpA, trpA-D64E, trpB, trpB-N185S, trpA-E. The position of each strain on the agar plate is detailed. The control of 0 μM compound is shown, and the growth of the strains were tested at 2× and 8× MIC of each compound.
